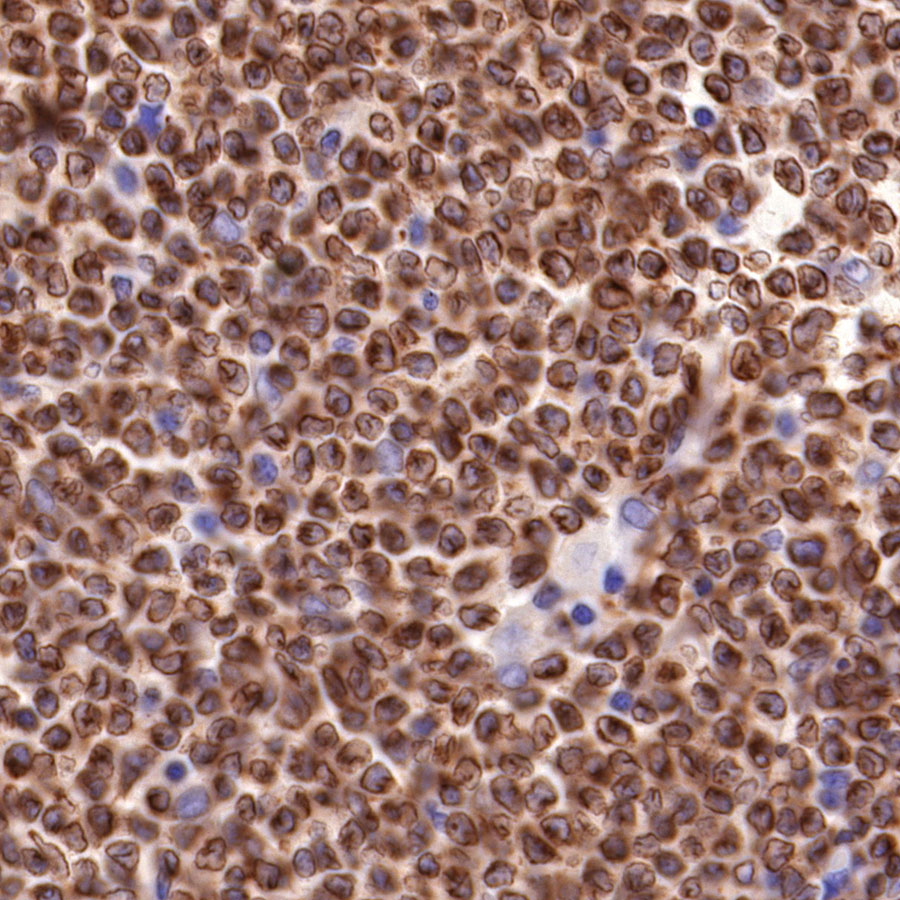

Product Details
Product Details
Product Specification
| Host | Rabbit |
| Antigen | Bcl-2 |
| Synonyms | B-cell lymphoma-2, Apoptosis regulator Bcl-2 |
| Immunogen | N/A |
| Location | Cytoplasm, Endoplasmic reticulum membrane, Mitochondrion outer membrane, Nucleus membrane |
| Accession | P10415 |
| Clone Number | SDT-R160 |
| Antibody Type | Recombinant mAb |
| Application | WB, IHC-P |
| Reactivity | Hu |
| Purification | Protein A |
| Concentration | 0.5 mg/ml |
| Physical Appearance | Liquid |
| Storage Buffer | PBS, 40% Glycerol, 0.05% BSA, 0.03% Proclin 300 |
| Stability & Storage | 12 months from date of receipt / reconstitution, -20 °C as supplied |
Dilution
| application | dilution | species |
| WB | 1:1000 | null |
| IHC-P | 1:1000 | null |
Background
Bcl-2 (B-cell lymphoma 2) is the founding member of the Bcl-2 family of regulator proteins that regulate cell death (apoptosis), by either inhibiting (anti-apoptotic) or inducing (pro-apoptotic) apoptosis. It was the first apoptosis regulator identified in any organism. Bcl-2 is localized to the outer membrane of mitochondria, where it plays an important role in promoting cellular survival and inhibiting the actions of pro-apoptotic proteins. Damage to the Bcl-2 gene has been identified as a cause of a number of cancers, including melanoma, breast, prostate, chronic lymphocytic leukemia, and lung cancer, and a possible cause of schizophrenia and autoimmunity. It is also a cause of resistance to cancer treatments.
Picture
Picture
Western Blot

Immunohistochemistry